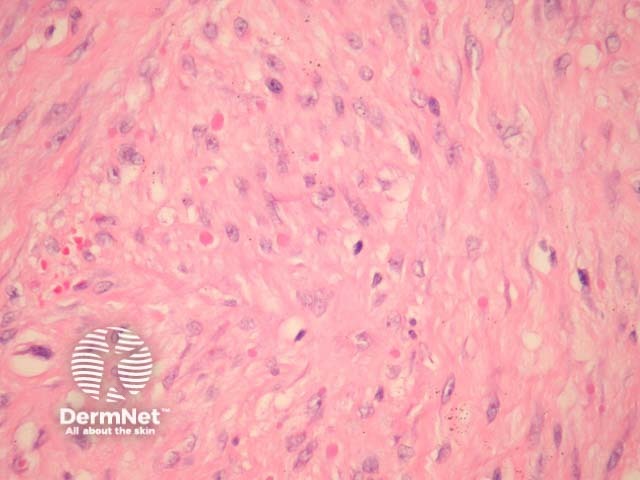
Figure 3
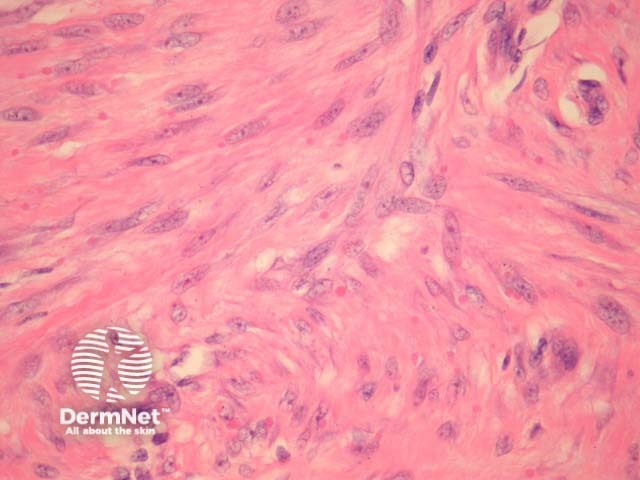
Figure 4

Main menu
Common skin conditions
NEWS
Join DermNet PRO
Read more
Quick links
Lesions (benign) Diagnosis and testing
Author: Assoc Prof Patrick Emanuel, Dermatopathologist, Auckland, New Zealand, 2013.
Introduction Histology Special studies Differential diagnoses
Infantile digital fibroma, also called inclusion body fibromatosis or Reye tumour, is a benign proliferation of myofibroblasts.
In infantile digital fibromatosis, sections show an intradermal unencapsulated tumour composed of spindle-shaped cells arranged in whorls or interdigitating sheets (figure 1). These myofibroblasts contain 3–10 μm inclusion bodies, which are round or ovoid and granular (figures 2-4, arrows are used to highlight some of the inclusion bodies in figure 2).
Earlier lesions of infantile digital fibromatosis are more inflammatory; more developed lesions display more fibroplasia and inclusion bodies.

Figure 1

Figure 2
Figure 3
Figure 4
The inclusion bodies stain pink with H&E (figures 2-4). The bodies are positive with immunohistochemical stains for actin and vimentin.
Fibromatosis – Identification of the characteristic inclusion bodies distinguish infantile digital fibromatosis from dermal fibromatosis and hypertrophic dermal scars